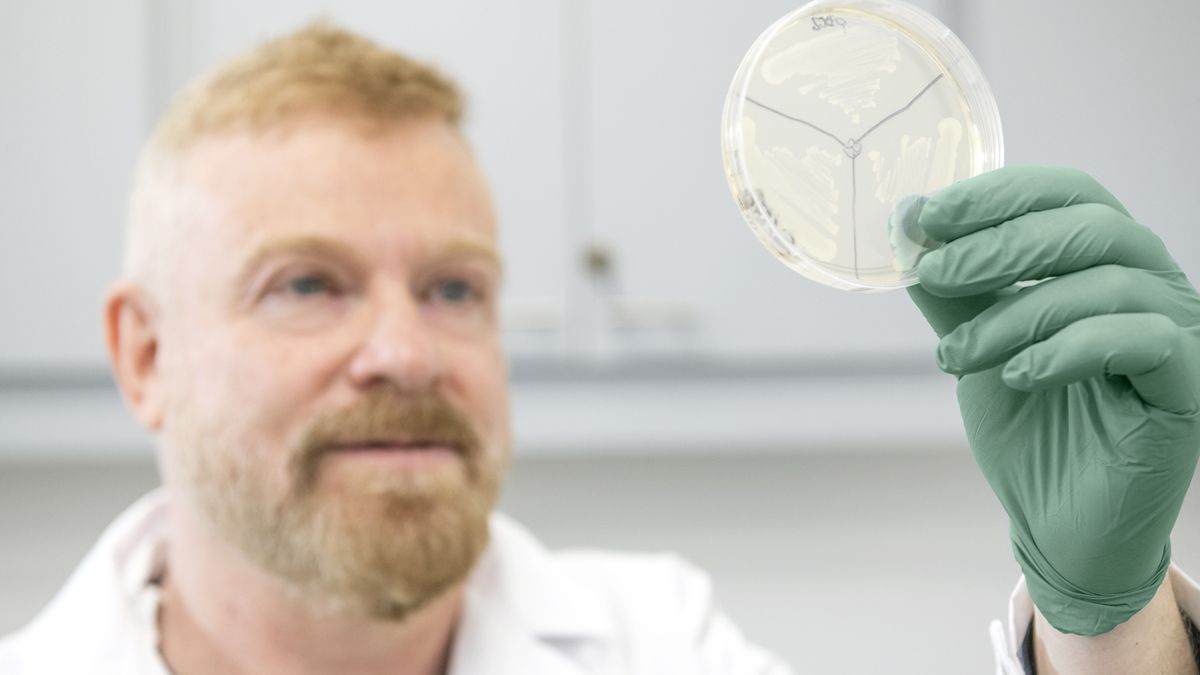

En septiembre pasado fue distinguido por la Fundación Konex con el ‘Premio Konex de Brillante 2023’ por sus descubrimientos, plasmados en 320 publicaciones, que revelaron un nuevo paradigma de control de la respuesta inmune, permitiendo el diseño de nuevas terapias basadas en la modulación de lectinas y glicanos en cáncer y enfermedades autoinmunes. Él es Gabriel Rabinovich, miembro de la Academia de Ciencias de EE.UU., América Latina, Argentina, TWAS, ANCEFN y European Molecular Biology Organization; Doctor Honoris Causa de diversas universidades. Recibió numerosos premios, la revista Immunity lo eligió entre las 25 voces de la Inmunología mundial, inventor de 10 patentes y co-fundador de la plataforma biotecnológica Galtec Life.
Sus equipos de trabajo lo señalan como un gran motivador en la labor diaria. “Trabajamos mucho en forma colectiva tratando de apoyarnos. A veces es muy difícil hacer ciencia de punta en la Argentina cuando uno tiene que trascender diferentes épocas con distintas condiciones económicas. Nosotros tenemos becarios, investigadores, técnicos, que entre todos se genera un apoyo muy grande y yo trato de impulsar que eso se haga realidad, pero no en la teoría sino en la práctica”, dijo Gabriel Rabinovich para Salud & Ciencia.
Nació en Córdoba capital, en Villa Cabrera, en 1969. Vivió 30 años en Córdoba, allí realizó su carrera en la Universidad Nacional de Córdoba, en la Facultad de Ciencias Químicas, y también su doctorado. Posteriormente se radicó en Buenos Aires, trabajó primero en la Facultad de Medicina de la Universidad de Buenos Aires y ahora en el Instituto de Biología y Medicina Experimental (Ibyme) en la Facultad de Ciencias Exactas y Naturales.
Rabinovich lanzó recientemente una empresa biotecnológica con inversión público-privada. Su objetivo es desarrollar terapias innovadoras contra el cáncer y las enfermedades autoinmunes basadas en una proteína clave: la Galectina-1. Como investigador, médico inmunólogo y glicobiólogo, tiene un talento innato para inspirar a otros y está profundamente comprometido con sus proyectos y con la ciencia transdisciplinaria. Desde su tesis doctoral en 1993 viene trabajando en Galectina-1, una proteína que tal como informara este medio en agosto de 2022, impacta en la actividad del reservorio de VIH latente, entre otras potencialidades.
“La inmunoterapia que se conoce hoy en día y que funciona en un 30% de los pacientes, está relacionada al bloqueo de moléculas inhibitorias negativas. Cuando el sistema inmune intenta llegar al tumor, hay barreras que impiden que los linfocitos puedan llegar y eliminar las células tumorales, y estas barreras están relacionadas con moléculas co-estimulatorias negativas, que son moléculas que bloquean la respuesta antitumoral. Nosotros lo que descubrimos es una molécula que está afuera del microambiente tumoral (afuera del tumor) y que cuando se acerca la respuesta inmune, también la bloquea, pero a su vez también contribuye a formar vasos sanguíneos: se trata de la Galectina-1.
¿De qué se trata esta empresa tecnológica recientemente inaugurada?
La empresa se llama Galtec y tiene la misión de traducir todos los descubrimientos que realizamos durante todos estos años, en tecnologías y en productos biofarmacéuticos para poder tratar tumores o enfermedades autoinmunes, que sería la otra cara de la moneda. Estamos poniendo toda nuestra energía y esto permitirá aumentar el número de pacientes que tengan la posibilidad de erradicar sus tumores. La empresa es privada, pero con patentes del Conicet que financió nuestra investigación a nivel de ciencia básica durante todos estos años. Hoy tenemos la posibilidad de transformar esas patentes en un medicamento, llevarlas a la clínica. Tenemos un convenio a partir del cual al Conicet le llegan regalías que equivalen a un porcentaje de las ventas o eventualmente de cada hito que se vaya cumpliendo. Esto significa un retorno a la institución que hizo esa inversión. Hay licenciamiento de las patentes y en este sentido fue pública y ahora es privada, no es que pertenece al Estado.
Usted descubre Galectina-1 en 1993…
Lo que se descubre es la función de Galectina-1 en el sistema inmunológico. Descubrimos la expresión de Galectina-1 en el sistema inmunológico. No existía, Galectina-1 como tal, sino que existían muchas lectinas en distintas especies. Nosotros descubrimos que Galectina-1 es inmunosupresora, que inhibe la respuesta inmunológica, que es antiinflamatoria, que modula la respuesta inmunológica y durante estos 30 años, con cada una de las tesis doctorales fuimos haciendo distintos descubrimientos que impactaron en lo que es ahora la Galectina-1.
¿Galectina-1 puede ser regulada en el organismo de acuerdo a lo que requiere el paciente?
Exactamente, de acuerdo a la condición patológica, de acuerdo a la enfermedad. Si es un cáncer, se bloquea la expresión de Galectina-1 y por eso hicimos un anticuerpo monoclonal neutralizante, que es uno de las tecnologías. Y si es una enfermedad autoinmune como esclerosis múltiple, trabajamos más que todo con una variante de Galectina-1 para el tratamiento de esa patología. De ese modo vamos modulando la proteína de acuerdo a la patología. Es como el yin y el yang.
Uno de sus trabajos sobre Galectina-1 en embarazadas fue publicado por la revista Nature…
Sí, además de ver el impacto sobre enfermedades, quisimos ver cuál es el rol fisiológico y en ese trabajo demostramos que durante el crecimiento del feto en el primer trimestre del embarazo se producen altos niveles de Galectina-1 en el trofoblasto (en la placenta). Lo que hace es eliminar a los linfocitos maternos que pueden dañar componentes propios porque sabemos que el feto que está creciendo es mitad de antígenos de la mamá y mitad del papá.
¿Cuáles son las perspectivas de la inmunoterapia en el mundo?
Los desafíos en este momento son aumentar la cantidad de pacientes que se beneficien, que sean más de 20 o 30% de pacientes. Por otro lado, además de eso, poder tener mejores biomarcadores que nos indiquen qué paciente se va a beneficiar y qué pacientes no se van a beneficiar de la inmunoterapia. Tratar de hacer medicina personalizada, tratar de ver qué pacientes son elegibles. Será positivo económicamente para poder seleccionar qué paciente van a responder y no generar toxicidad, es decir, disminuir los efectos tóxicos, porque todos estos tratamientos están asociados a algunos elementos tóxicos. El futuro es tratar de incrementar el número de terapias dentro de la inmunoterapia que traten de bloquear distintos mecanismos de escape tumoral.
Unas semanas previas a esta entrevista, Rabinovich dijo en una conferencia que “la inmunoterapia es un conjunto de estrategias terapéuticas que involucra la estimulación o reprogramación de nuestro sistema inmunológico para poder prever, suprimir o atenuar tumores, logrando aumentar la sobrevida global en pacientes con una diversidad muy grande de tumores, desde el melanoma, pulmonar, renal, cáncer de cabeza y cuello, colorrectal, gástricos y la lista aumenta cada año”.
Por Fernanda Bireni